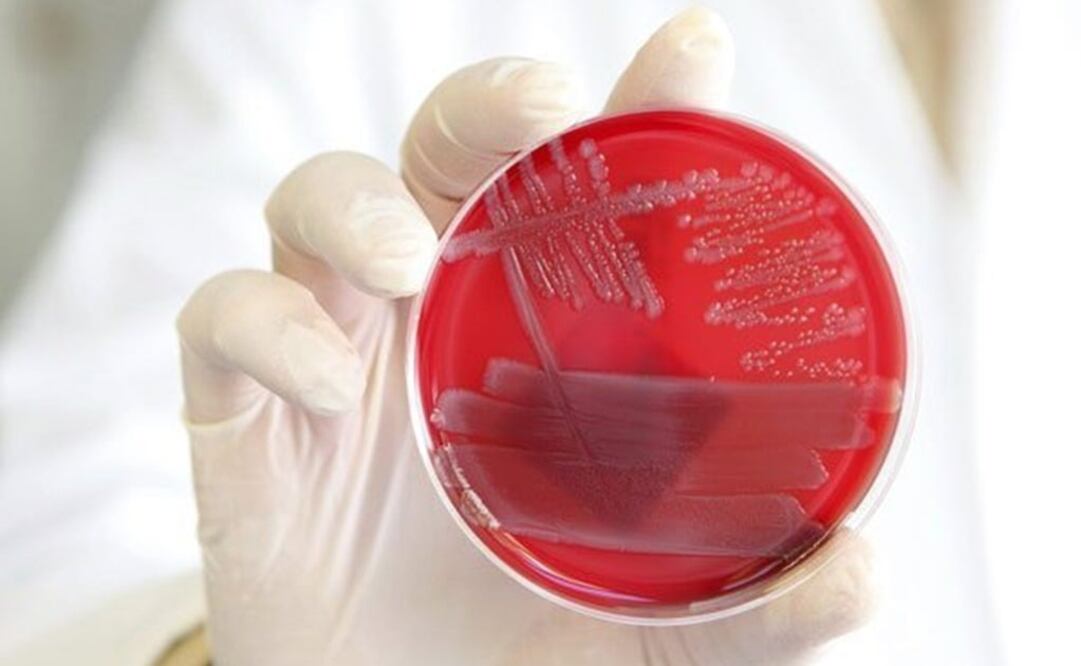
Una muestra de Escherichia coli enterohemorrágica. Foto: EFE

El pasado martes, autoridades sanitarias de Estados Unidos y Canadá pidieron a las personas que eviten comer lechuga romana debido a un nuevo brote de E. coli.
La Escherichia coli (E. coli) es una bacteria que se encuentra normalmente en el intestino del ser humano y de otros animales. “Aunque no parece que su presencia tenga una función especialmente relevante, se ha descrito que la bacteria E. coli favorece la absorción de algunas vitaminas, especialmente la vitamina K”, explica José María Marimón, experto de la Sociedad Española de Enfermedades Infecciosas y Microbiología Clínica (SEIMC).
Sin embargo, la bacteria E. coli “también es la causa más frecuente de infección urinaria y, en menor medida, de otras infecciones como meningitis en el neonato o infecciones respiratorias”, precisa.
El doctor Marimón expone que los tipos de E. coli que causan diarrea se transmiten fundamentalmente por vía oral , al ingerir agua o alimentos contaminados . “También se pueden transmitir a través del contacto directo con personas o animales infectados , pero esta es una vía mucho menos frecuente”, asegura.
Según indican los especialistas de los Centros para el Control y la Prevención de Enfermedades de Estados Unido s (CDC por sus siglas en inglés), la bacteria puede mezclarse accidentalmente con la carne picada antes de que sea empaquetad a y también puede propagarse en la carne que no ha sido suficientemente cocinada, aunque su aspecto y su olor sean normales.
“La bacteria también puede vivir en las ubres de las vacas y puede llegar a la leche que no está pasteurizada. Las hortalizas y las frutas que han sido regados o lavados con agua sucia pueden ser, asimismo, portadores”, sostienen.
Además, la bacteria Escherichia coli puede propagarse “a través de las personas que no se lavan las manos después de ir al baño y de los niños que usan pañales, cuando los adultos que los cambian no se lavan bien”, aclaran.
La Organización Mundial de la Salud expresa que, para prevenir la infección, hay que aplicar medidas de control en todas las etapas de la cadena alimentaria, desde la producción agropecuaria en la granja hasta la elaboración, f abricación y preparación de los alimento s en las cocinas de establecimientos comerciales y hogares.
Noticias según tus intereses
[Publicidad]
[Publicidad]